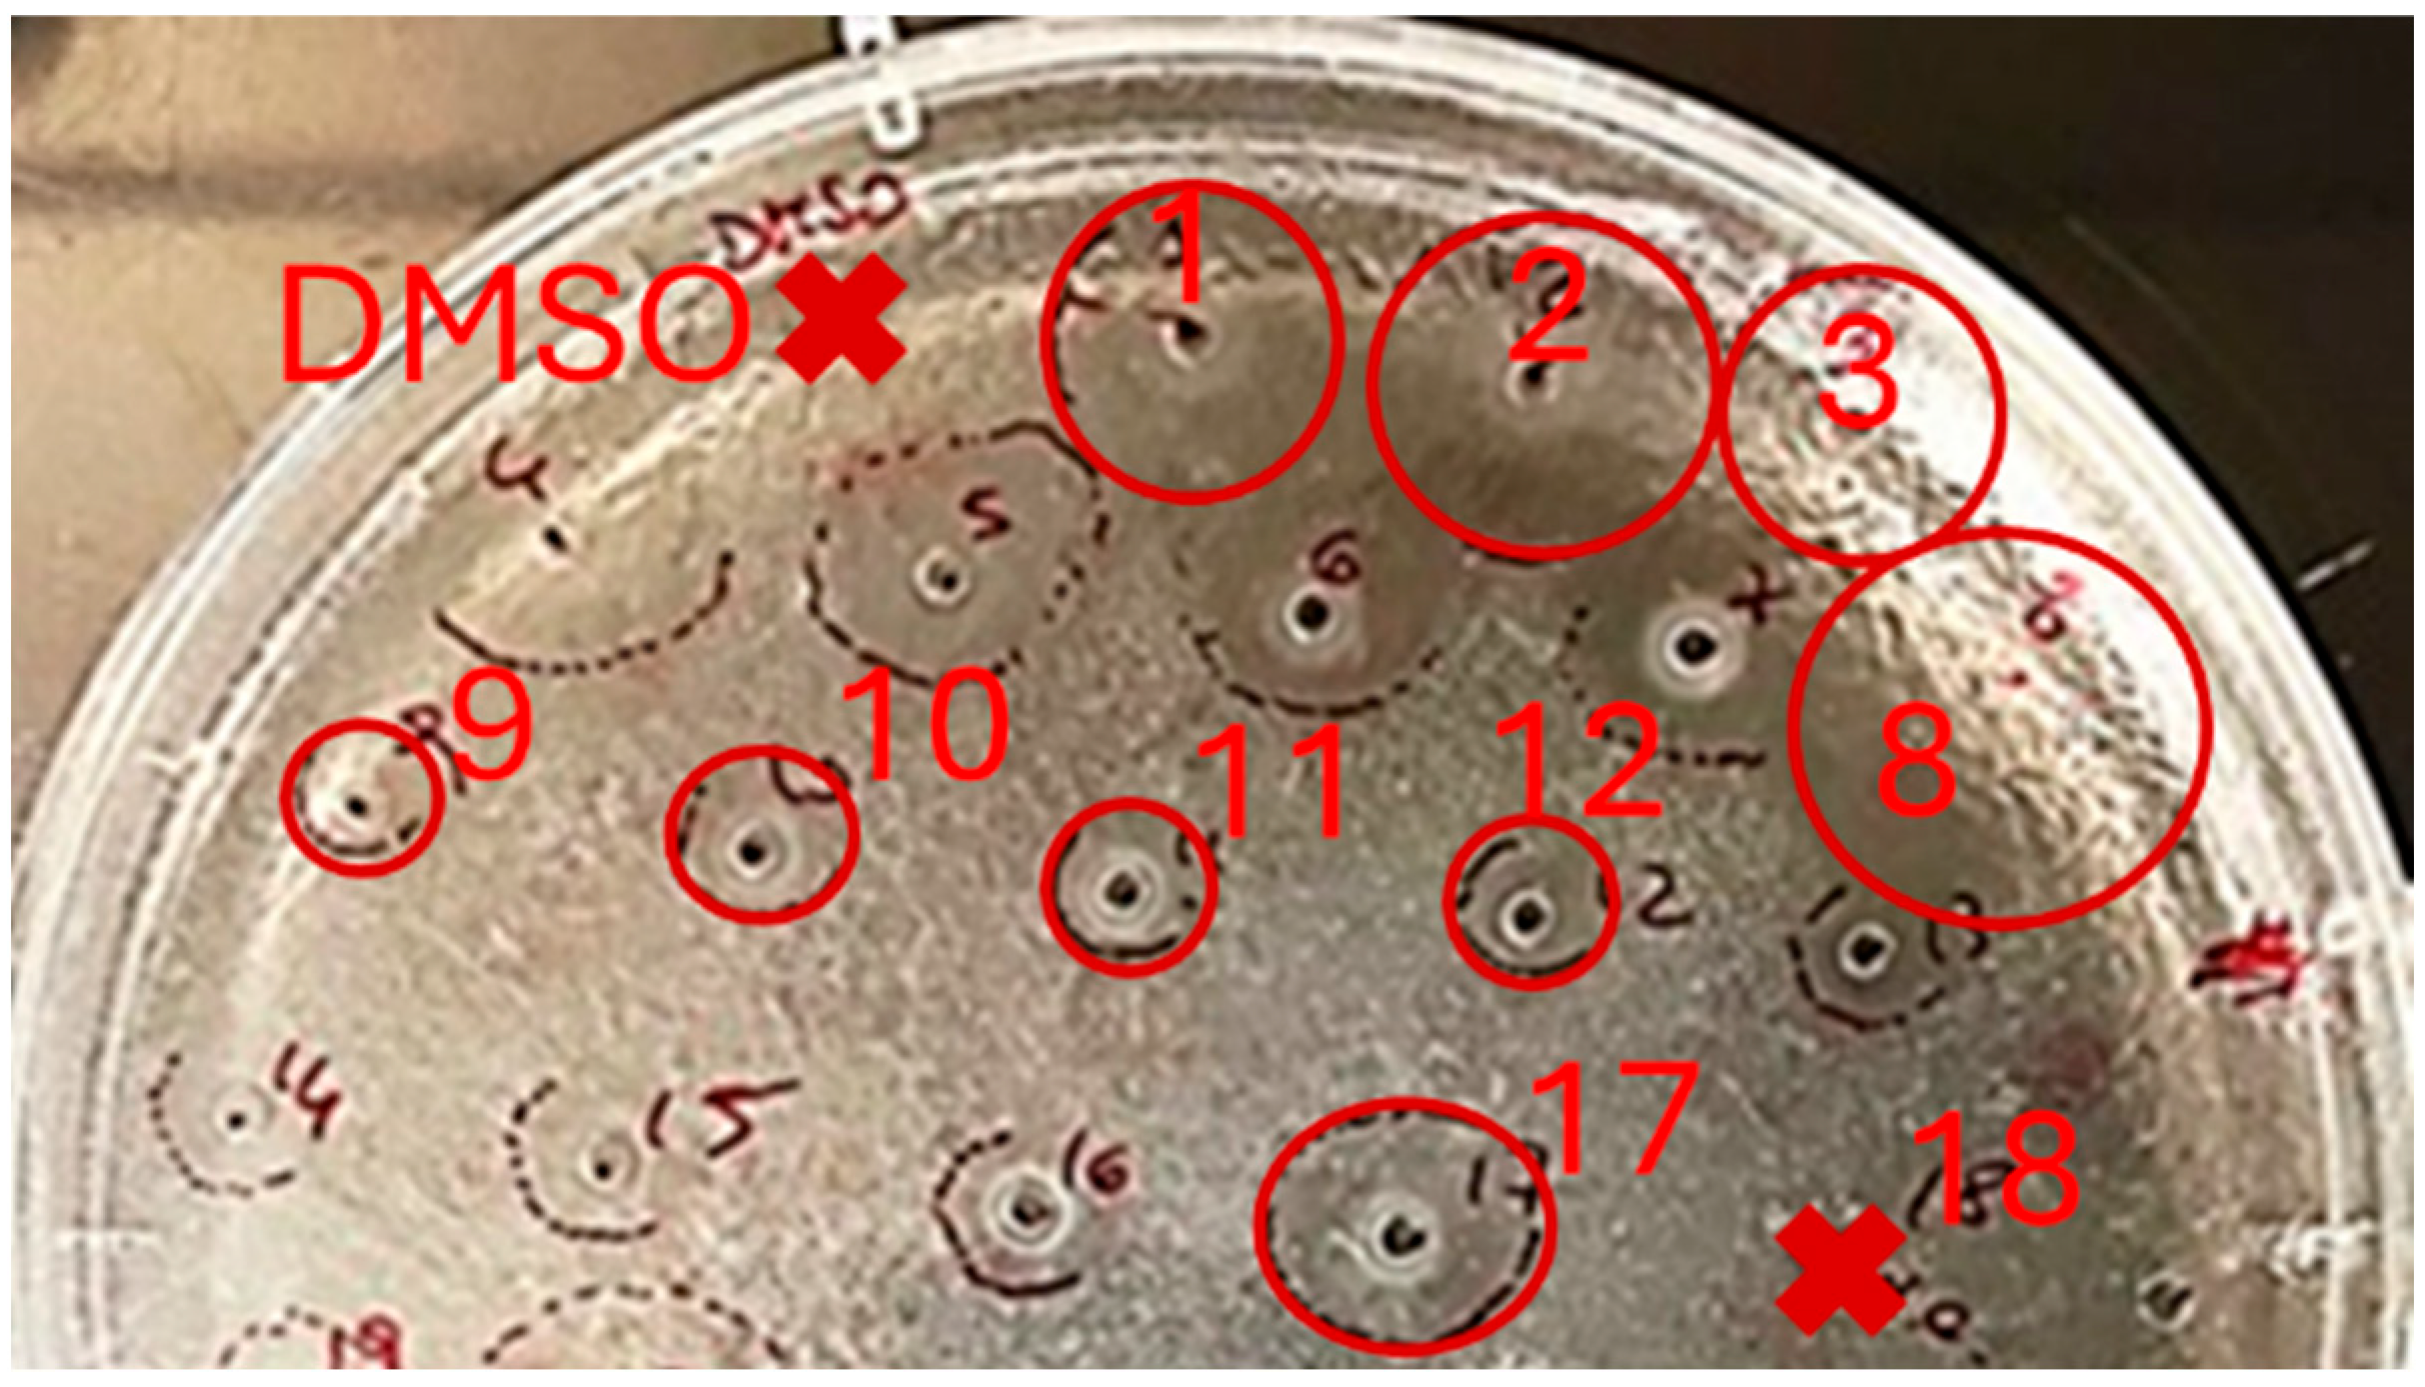

Exploring the Chemical Composition and Antimicrobial Activity of Extracts from the Roots and Aboveground Parts of Limonium gmelini
Abstract
1. Introduction
2. Results and Discussion
2.1. Comparative Analysis of the Methods for Obtaining Plant Extracts from the Roots and Aboveground Parts of L. gmelini
2.2. Monosaccharide Composition
2.3. Study of the Antibacterial Activity of L. gmelini Plant Extracts
2.4. 1H-NMR Analysis of Extracts Purified by Solid-Phase Extraction
3. Materials and Methods
3.1. Plant Material
3.2. Sample Preparation
3.3. Chemicals and Reagents
3.4. Extraction of Biologically Active Compounds
3.4.1. Ultrasound-Assisted Extraction (UAE)
3.4.2. Conventional Maceration (CM)
3.4.3. Supercritical Fluid Extraction (SFE)
3.4.4. Solid Phase Extraction (SPE)
3.5. Study of Monosaccharide Composition
3.6. In Vitro Antibacterial Activity Study Using Agar Diffusion Method and Microdilution Broth Assay
3.7. 1H-NMR Analysis
3.8. Statistical Analysis
4. Conclusions
Author Contributions
Funding
Institutional Review Board Statement
Informed Consent Statement
Data Availability Statement
Conflicts of Interest
References
- Malekmohammadi, M.; Lack, H.W.; Lomonosova, M.; Akhani, H. The discovery, naming and typification of Limonium gmelini (Plumbaginaceae). Willdenowia 2017, 47, 201–214. [Google Scholar] [CrossRef]
- Tuohongerbieke, A.; Li, J.; Sabir, G.; Xin, X.; Hu, M.; Duan, X.; Liu, L.; Tang, D.; Zhu, J.; Aisa, H.A. Lignanamides from the roots of Limonium gmelinii (Willd.) Kuntze and their anti-diabetic, cytotoxic and anti-inflammatory activities. Phytochemicals 2021, 184, 112648. [Google Scholar] [CrossRef] [PubMed]
- Zhusupova, G.; Abil’kaeva, S. Flavanes from Limonium gmelinii. II. Chem. Nat. Compd. 2006, 42, 112–113. [Google Scholar] [CrossRef]
- Kozhamkulova, Z.; Gadetskaya, A.; Nurbossynova, S.; Zhussupova, G.; Abilov, Z.; Ross, S. Biologically active compounds of aboveground part of Limonium gmelinii. Chem. Bull. Kaz. Natl. Univ. 2011, 61, 125–129. [Google Scholar]
- Tuohongerbieke, A.; Liu, L.; Li, J.; Xin, X.; Aisa, H.A. Root-Extracted lignanamides from Limonium gmelinii (Willd.) Kuntze with a potential PTP1B inhibitory activity by regulating PI3K/AKT signaling pathway. Bioorganic Chem. 2023, 132, 106348. [Google Scholar] [CrossRef] [PubMed]
- Tuohongerbieke, A.; Kaiyrkulova, A.; Guan, Y.Q.; Zhu, J.; Shi, L.L.; Sabir, G.; Aisa, H.A. Chemical constituents of Limonium gmelinii roots. Chem. Nat. Compd. 2019, 55, 734–735. [Google Scholar] [CrossRef]
- Gadetskaya, A.V.; Mohamed, S.M.; Tarawneh, A.H.; Mohamed, N.M.; Ma, G.; Ponomarev, B.N.; Zhusupova, G.E.; Cantrell, C.L.; Cutler, S.J.; Ross, S.A. Phytochemical characterization and biological activity of secondary metabolites from three Limonium species. Med. Chem. Res. 2017, 26, 2743–2750. [Google Scholar] [CrossRef]
- Nurkenov, T.; Tsoy, A.; Olzhayev, F.; Abzhanova, E.; Turgambayeva, A.; Zhussupova, A.; Avula, B.; Ross, S.; Aituarova, A.; Kassymova, D.; et al. Plant extract of Limonium gmeliniiattenuates oxidative responses in neurons, astrocytes, and cerebral endothelial cells in vitro and improves motor functions of rats after middle cerebral artery occlusion. Antioxidants 2021, 10, 1814. [Google Scholar] [CrossRef] [PubMed]
- Çinar, G.A.; Alagöz, Z. Investigation of the Usage of Limonium gmelinii in Phytoremediation. Univers. J. Plant Sci. 2022, 9, 33–43. [Google Scholar] [CrossRef]
- Fedorov, A.A. Plant Resources of the USSR. Flowering Plants, Their Chemical Composition, Use. Families Magnoliaceae-Limoniaceae; Nauka: Leningrad, Russia, 1984; 460p. [Google Scholar]
- Zhussupova, A.; Zhussupova, G.; Gadetskaya, A. Creation of medicinal products on the basis of Limonium gmelinii. Planta Med. 2015, 81, PM_45. [Google Scholar] [CrossRef]
- Kassymova, D.; Zhusupova, G.; Ogay, V.; Zhussupova, A.; Katragunta, K.; Avula, B.; Khan, I.A. Phytochemical Profiles and In Vitro Immunomodulatory Activities of Extracts Obtained from Limonium gmelinii Using Different Extraction Methods. Plants 2023, 12, 4019. [Google Scholar] [CrossRef] [PubMed]
- Azwanida, N.N. A review on the extraction methods use in medicinal plants, principle, strength and limitation. Med. Aromat. Plants 2015, 4, 196. [Google Scholar] [CrossRef]
- Bitwell, C.; Indra, S.S.; Luke, C.; Kakoma, M.K. A review of modern and conventional extraction techniques and their applications for extracting phytochemicals from plants. Sci. Afr. 2023, 19, e01585. [Google Scholar] [CrossRef]
- Kishore, N.; Kumar, P.; Shanker, K.; Verma, A.K. Human disorders associated with inflammation and the evolving role of natural products to overcome. Eur. J. Med. Chem. 2019, 179, 272–309. [Google Scholar] [CrossRef] [PubMed]
- Murphy, E.J.; Fehrenbach, G.W.; Abidin, I.Z.; Buckley, C.; Montgomery, T.; Pogue, R.; Murray, P.; Major, I.; Rezoagli, E. Polysaccharides—Naturally occurring immune modulators. Polymers 2023, 15, 2373. [Google Scholar] [CrossRef] [PubMed]
- Gan, Q.X.; Wang, J.; Hu, J.; Lou, G.H.; Xiong, H.J.; Peng, C.Y.; Huang, Q.W. Modulation of apoptosis by plant polysaccharides for exerting anti-cancer effects: A review. Front. Pharmacol. 2020, 11, 792. [Google Scholar] [CrossRef] [PubMed]
- Salehi, M.; Rashidinejad, A. Multifaceted roles of plant-derived bioactive polysaccharides: A review of their biological functions, delivery, bioavailability, and applications within the food and pharmaceutical sectors. Int. J. Biol. Macromol. 2025, 290, 138855. [Google Scholar] [CrossRef] [PubMed]
- Huo, J.; Wu, Z.; Zhao, H.; Sun, W.; Wu, J.; Huang, M.; Zhang, J.; Wang, Z.; Sun, B. Structure-activity relationship of antioxidant polysaccharides from Huangshui based on the HPLC fingerprint combined with chemometrics methods. LWT 2022, 159, 113201. [Google Scholar] [CrossRef]
- Wang, Z.; Zheng, Y.; Lai, Z.; Hu, X.; Wang, L.; Wang, X.; Li, Z.; Gao, M.; Yang, Y.; Wang, Q.; et al. Effect of monosaccharide composition and proportion on the bioactivity of polysaccharides: A review. Int. J. Biol. Macromol. 2024, 254, 127955. [Google Scholar] [CrossRef] [PubMed]
- Rasul, M.G. Conventional extraction methods use in medicinal plants, their advantages and disadvantages. Int. J. Basic Sci. Appl. Comput. 2018, 2, 10–14. [Google Scholar]
- Tilley, A.; McHenry, M.P.; McHenry, J.A.; Solah, V.; Bayliss, K. Enzymatic browning: The role of substrates in polyphenol oxidase mediated browning. Curr. Res. Nutr. Food Sci. 2023, 7, 100623. [Google Scholar] [CrossRef] [PubMed]
- Khadhraoui, B.; Ummat, V.; Tiwari, B.; Fabiano-Tixier, A.; Chemat, F. Review of ultrasound combinations with hybrid and innovative techniques for extraction and processing of food and natural products. Ultrason. Sonochem. 2021, 76, 105625. [Google Scholar] [CrossRef] [PubMed]
- Tiwari, B.K. Ultrasound: A clean, green extraction technology. TrAC Trends Anal. Chem. 2015, 71, 100–109. [Google Scholar] [CrossRef]
- Uwineza, P.A.; Waśkiewicz, A.J.M. Recent advances in supercritical fluid extraction of natural bioactive compounds from natural plant materials. Molecules 2020, 25, 3847. [Google Scholar] [CrossRef] [PubMed]
- Chiriac, E.R.; Chiţescu, C.L.; Geană, E.I.; Gird, C.E.; Socoteanu, R.P.; Boscencu, R. Advanced analytical approaches for the analysis of polyphenols in plants matrices—A review. Separations 2021, 8, 65. [Google Scholar] [CrossRef]
- Mencin, M.; Mikulic-Petkovsek, M.; Veberič, R.; Terpinc, P. Development and optimisation of solid-phase extraction of extractable and bound phenolic acids in spelt (Triticum spelta L.) seeds. Antioxidants 2021, 10, 1085. [Google Scholar] [CrossRef] [PubMed]
- Casillo, A.; Fabozzi, A.; Russo Krauss, I.; Parrilli, E.; Biggs, C.I.; Gibson, M.I.; Lanzetta, R.; Appavou, M.-S.; Radulescu, A.; Tutino, M.L.; et al. Physicochemical approach to understanding the structure, conformation, and activity of mannan polysaccharides. Biomacromolecules 2021, 22, 1445–1457. [Google Scholar] [CrossRef] [PubMed]
- Wang, B.; Yan, L.; Guo, S.; Wen, L.; Yu, M.; Feng, L.; Jia, X. Structural elucidation, modification, and structure-activity relationship of polysaccharides in Chinese herbs: A review. Front. Nutr. 2022, 9, 908175. [Google Scholar] [CrossRef] [PubMed]
- Jiang, X.-L.; Ma, G.-F.; Zhao, B.-B.; Meng, Y.; Chen, L.-L. Structural characterization and immunomodulatory activity of a novel polysaccharide from Panax notoginseng. Front. Pharmacol. 2023, 14, 1190233. [Google Scholar] [CrossRef] [PubMed]
- Qu, J.; Huang, P.; Zhang, L.; Qiu, Y.; Qi, H.; Leng, A.; Shang, D. Hepatoprotective effect of plant polysaccharides from natural resources: A review of the mechanisms and structure-activity relationship. Int. J. Biol. Macromol. 2020, 161, 24–34. [Google Scholar] [CrossRef] [PubMed]
- Wu, D.T.; Meng, L.Z.; Wang, L.Y.; Lv, G.P.; Cheong, K.L.; Hu, D.J.; Guan, J.; Zhao, J.; Li, S.P. Chain conformation and immunomodulatory activity of a hyperbranched polysaccharide from Cordyceps sinensis. Carbohydr. Polym. 2014, 110, 405–414. [Google Scholar] [CrossRef] [PubMed]
- Christophoridou, S.; Dais, P. Detection and quantification of phenolic compounds in olive oil by high resolution 1H nuclear magnetic resonance spectroscopy. Anal. Chim. Acta 2009, 633, 283–292. [Google Scholar] [CrossRef] [PubMed]
- Cairone, F.; Petralito, S.; Scipione, L.; Cesa, S. Study on Extra Virgin Olive Oil: Quality evaluation by anti-radical activity, color analysis, and polyphenolic HPLC-DAD analysis. Foods 2021, 10, 1808. [Google Scholar] [CrossRef] [PubMed]
- Campos, J.F.; dos Santos, U.P.; Macorini, L.F.B.; de Melo, A.M.M.F.; Balestieri, J.B.P.; Paredes-Gamero, E.J.; Cardoso, C.A.L.; de Picoli Souza, K.; dos Santos, E.L. Antimicrobial, antioxidant and cytotoxic activities of propolis from Melipona orbignyi (Hymenoptera, Apidae). Food Chem. Toxicol. 2014, 65, 374–380. [Google Scholar] [CrossRef] [PubMed]
- Cairone, F.; Salvitti, C.; Iazzetti, A.; Fabrizi, G.; Troiani, A.; Pepi, F.; Cesa, S. In-depth chemical characterization of Punica granatum L. seed oil. Foods 2023, 12, 1592. [Google Scholar] [CrossRef] [PubMed]
- Yang, Y.; Li, M.; Sun, J.; Qin, S.; Diao, T.; Bai, J.; Li, Y. Microwave-assisted aqueous two-phase extraction of polysaccharides from Hippophae rhamnoide L.: Modeling, characterization and hypoglycemic activity. Int. J. Biol. Macromol. 2024, 254 Pt 1, 127626. [Google Scholar] [CrossRef] [PubMed]
- Liu, C.; Dai, K.Y.; Li, Z.T.; Liu, A.J. Comparison of two kinds of Agrocybe cylindracea polysaccharides: Structural characteristic and antitumor activity. Food Bioprod. Process. 2023, 140, 160–171. [Google Scholar] [CrossRef]
- Casciaro, B.; Ghirga, F.; Cappiello, F.; Vergine, V.; Loffredo, M.R.; Cammarone, S.; Puglisi, E.; Tortora, C.; Quaglio, D.; Mori, M.L. The triprenylated anthranoid ferruginin a, a promising scaffold for the development of novel antibiotics against gram-positive bacteria. Antibiotics 2022, 11, 84. [Google Scholar] [CrossRef] [PubMed]
- Ambroselli, D.; Masciulli, F.; Romano, E.; Guerrini, R.; Ingallina, C.; Spano, M.; Mannina, L. NMR Metabolomics of Arctium lappa L., Taraxacum officinale and Melissa officinalis: A Comparison of Spontaneous and Organic Ecotypes. Foods 2024, 13, 1642. [Google Scholar] [CrossRef] [PubMed]
- Zhussupova, A.; Zhumaliyeva, G.; Ogay, V.; Issabekova, A.; Ross, S.A.; Zhusupova, G.E. Immunomodulatory Effects of Plant Extracts from Salvia deserta Schang. and Salvia sclarea L. Plants 2022, 11, 2690. [Google Scholar] [CrossRef] [PubMed]

| Sample | Rha | Xyl | Ara | GlcA | GalA | Man | Gal | Glc |
|---|---|---|---|---|---|---|---|---|
| 1a (UAE, roots) | 9.7 | 13.9 | <0.5 | <0.5 | 3.0 | 72.7 | ||
| 1b (CM, roots) | 10.1 | 16.5 | <0.5 | 0.5 | 3.4 | 69.3 | ||
| 1c (SFE, roots) | 11.3 | 10.3 | <0.5 | 0.8 | 2.4 | 75.1 | ||
| 1c1 (Aqueous fraction from the roots SPE extract) | 4.3 | 1.6 | <0.5 | 0.7 | 1.6 | 91.5 | ||
| 2a (UAE, aboveground parts) | 10.5 | 2.0 | 7.6 | 2.0 | 1.1 | 1.4 | 11.1 | 64.3 |
| 2b (CM, aboveground parts) | 11.0 | 2.1 | 6.2 | 2.0 | 1.1 | 1.6 | 11.5 | 64.5 |
| 2c (SFE, aboveground parts) | 10.9 | 1.6 | 2.7 | 1.9 | 0.7 | 1.1 | 7.8 | 73.3 |
| 2c1 (Aqueous fraction from the aboveground parts SPE extract) | 4.8 | 1.4 | 1.5 | 0.6 | 0.4 | 1.0 | 3.3 | 87.0 |
| Monosaccharide | Xyl | Ara | Rha |
|---|---|---|---|
| Sample | |||
| Root extracts | - | Terminal-Ara | Terminal-Rha 3,4-Rha |
| Aboveground parts extracts | Terminal-Xyl | Terminal-Ara | 3,4-Rha |
| No. | Sample | Inhibition Zone (mm) | |
|---|---|---|---|
| E. coli ATCC 25922 | S. epidermidis ATCC 12228 | ||
| 1 | 1a (UAE, root) | n.a. | 13.4 ± 3.7 |
| 2 | 1b (CM, root) | n.a. | 14.3 ± 4.6 |
| 3 | 1c (SFE, root) | n.a. | 12.9 ± 3.5 |
| 8 | 1c2 (Methanol fraction from root extract, SPE) | n.a. | 19.1 ± 1.4 |
| 9 | 1c1 (Aqueous fraction from root extract, SPE) | n.a. | 6.3 ± 0.2 |
| 10 | 2a (UAE, aboveground part) | n.a. | 8.6 ± 0.2 |
| 11 | 2b (CM, aboveground part) | n.a. | 8.7 ± 1.2 |
| 12 | 2c (SFE, aboveground part) | n.a. | 9.3 ± 2.1 |
| 17 | 2c2 (Methanol fraction from aboveground parts extract, SPE) | n.a. | 16.2 ± 2.3 |
| 18 | 2c1 (Aqueous fraction from aboveground parts extract, SPE) | n.a. | n.a. |
| DMSO (100%) | n.a. | n.a. | |
| No. | Sample | IC50 (µg/mL) | IC90 (µg/mL) |
|---|---|---|---|
| 1 | 1a (UAE, root) | 120.9 | 1155.3 |
| 2 | 1b (CM, root) | 152.4 | 2481.7 |
| 3 | 1c (SFE, root) | 219.2 | 798.7 |
| 8 | 1c2 (Methanol fraction from root extract, SPE) | 101.7 | 1059.3 |
| 9 | 1c1 (Aqueous fraction from root extract, SPE) | 964.3 | 3797.5 |
| 10 | 2a (UAE, aboveground part) | 51.2 | 162.7 |
| 11 | 2b (CM, aboveground part) | 139.3 | 723.0 |
| 12 | 2c (SFE, aboveground part) | 118.2 | 2195.1 |
| 17 | 2c2 (Methanol fraction from aboveground parts extract, SPE) | 101.9 | 459.1 |
| 18 | 2c1 (Aqueous fraction from aboveground parts extract, SPE) | 185.3 | 3629.3 |
| Compound | Assignment | 1H (ppm) | Multiplicity [J(Hz)] | 13C (ppm) | 1c2 mg/100g | 2c2 mg/100g |
|---|---|---|---|---|---|---|
| Gallic Acid | CH-2, CH-6 | 7.05 * | s | 110.9 | 543.20 ± 0.05 | 353.58 ± 0.04 |
| COOH | 170.2 | |||||
| Myricetin | CH-8 | 6.37 * | d [2.2] | 95.0 | 507.02 ± 0.07 | 335.56 ± 0.10 |
| CH-6 | 6.18 | d [2.2] | 100.0 | |||
| CH-2′, CH-6′ | 7.30 | s | 110.3 | |||
| Naringenin | CH-3a, CH-3b | 2.68, 3.10 | dd, dd [17.0; 3.0] | 42.7 | 162.07 ± 0.09 | 559.70 ± 0.04 |
| CH-2 | 5.30 | dd [12.6, 2.7] | 79.0 | |||
| CH-6 | 5.88 | d [2.1] | 95.7 | |||
| CH-8 | 5.90 * | d [2.1] | 94.9 | |||
| CH-2′, CH-6′ | 6.80 | m | 115.0 | |||
| CH-3′, CH-5′ | 7.30 | m | 127.8 | |||
| Tyramine | CH2-7 | 2.90 | t [7.3] | 30.7 | n.d. | 341.34 ± 0.05 |
| CH2-8 | 3.22 | t [7.3] | 41.9 | |||
| CH-2, CH-6 | 6.90 * | d [8.3] | 115.5 | |||
| CH-3, CH-5 | 7.21 | d [8.3] | 131.3 |
Disclaimer/Publisher’s Note: The statements, opinions and data contained in all publications are solely those of the individual author(s) and contributor(s) and not of MDPI and/or the editor(s). MDPI and/or the editor(s) disclaim responsibility for any injury to people or property resulting from any ideas, methods, instructions or products referred to in the content. |
© 2025 by the authors. Licensee MDPI, Basel, Switzerland. This article is an open access article distributed under the terms and conditions of the Creative Commons Attribution (CC BY) license (https://creativecommons.org/licenses/by/4.0/).
Share and Cite
Kassymova, D.; Cairone, F.; Ambroselli, D.; Lanzetta, R.; Casciaro, B.; Zhussupova, A.; Quaglio, D.; Casillo, A.; Zhusupova, G.E.; Corsaro, M.M.; et al. Exploring the Chemical Composition and Antimicrobial Activity of Extracts from the Roots and Aboveground Parts of Limonium gmelini. Molecules 2025, 30, 3024. https://doi.org/10.3390/molecules30143024
Kassymova D, Cairone F, Ambroselli D, Lanzetta R, Casciaro B, Zhussupova A, Quaglio D, Casillo A, Zhusupova GE, Corsaro MM, et al. Exploring the Chemical Composition and Antimicrobial Activity of Extracts from the Roots and Aboveground Parts of Limonium gmelini. Molecules. 2025; 30(14):3024. https://doi.org/10.3390/molecules30143024
Chicago/Turabian StyleKassymova, Dariya, Francesco Cairone, Donatella Ambroselli, Rosa Lanzetta, Bruno Casciaro, Aizhan Zhussupova, Deborah Quaglio, Angela Casillo, Galiya E. Zhusupova, Maria Michela Corsaro, and et al. 2025. "Exploring the Chemical Composition and Antimicrobial Activity of Extracts from the Roots and Aboveground Parts of Limonium gmelini" Molecules 30, no. 14: 3024. https://doi.org/10.3390/molecules30143024
APA StyleKassymova, D., Cairone, F., Ambroselli, D., Lanzetta, R., Casciaro, B., Zhussupova, A., Quaglio, D., Casillo, A., Zhusupova, G. E., Corsaro, M. M., Botta, B., Cammarone, S., Mangoni, M. L., Ingallina, C., & Ghirga, F. (2025). Exploring the Chemical Composition and Antimicrobial Activity of Extracts from the Roots and Aboveground Parts of Limonium gmelini. Molecules, 30(14), 3024. https://doi.org/10.3390/molecules30143024

